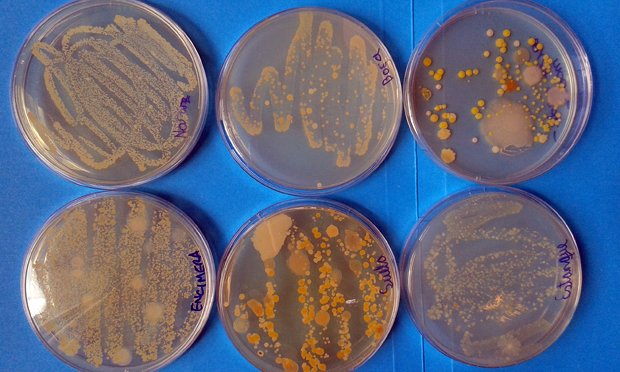
Imagen relacionada

Esc Primitiva Echeverría 7ºB Valeria Paz Aravena Queupumil
jueves, 12 de septiembre de 2019
jueves, 5 de septiembre de 2019
Desalinización del agua en Chile.
La desalinización del agua de mar es un método que se viene utilizando desde hace muchísimo tiempo. Los marineros griegos hervían el agua para sacarle la sal, y los romanos usaban filtros de arcilla para atraparla. Así que esto de nuevo no tiene nada, aunque obviamente hoy se utilizan métodos más sofisticados y las plantas de desalinización se han ido multiplicando. La desalinización se puede realizar de varias formas, pero hay dos que son las más comunes, la primera imita el ciclo natural de evaporación y lluvia a través de métodos que usan calor y, con diferentes variantes, evaporan el agua y la vuelven a condensar. Y la otra se basa en membranas que permiten separar el agua de la sal (pero para lograrlo se necesita mucha energía). Este método es más conocido como ósmosis inversa y lo utilizan el 70% de las plantas del mundo, incluso las que hay en Chile.




lunes, 5 de agosto de 2019
cultivo de Hongos (beneficios)
martes, 30 de julio de 2019
lunes, 29 de julio de 2019
Virus.
En biología, un virus o virus biológico es un agente infeccioso microscópico acelular que solo puede multiplicarse dentro de las células de otros organismos. Los virus infectan a todo tipo de organismos, desde animales, hongos, plantas, hasta bacterias y arqueas.

https://www.google.com/search?q=virus&rlz=1C1CHBF_esCL839CL846&source=lnms&tbm=isch&sa=X&ved=0ahUKEwjKr9PcrtrjAhVsK7kGHdW1BSMQ_AUIESgB&biw=1600&bih=757#imgrc=iIBN4rD5-2iP8M:

https://www.google.com/search?q=virus&rlz=1C1CHBF_esCL839CL846&source=lnms&tbm=isch&sa=X&ved=0ahUKEwjKr9PcrtrjAhVsK7kGHdW1BSMQ_AUIESgB&biw=1600&bih=757#imgrc=iIBN4rD5-2iP8M:
martes, 28 de mayo de 2019
Crisis de Venezuela
La crisis presidencial de Venezuela de 2019 es una crisis política en torno a la Legitimidad de quién ocupa la presidencia de Venezuela, después de que el 10 de enero de 2019 la Asamblea Nacional de Venezuela declarara que Nicolas Maduro estaba usurpando el cargo de presidente y Juan Guaidó —en calidad de Presidente de la Asamblea Nacional— tomara juramento como presidente encargado del país.
Venezuela arrastra una crisis institucional desde 2016, cuando el Tribunal Supremo de Justicia (TSJ), cuya designación es cuestionada por la opsición, ordenó la desincorporación de tres diputados del Estado Amazonas que habían sido acusados por la supuesta compra de votos. Sin estos diputados, la oposición perdía la Mayoría calificada en el parlamento venezolano.

https://www.google.com/search?q=crisis+de+venezuela+2019&rlz=1C1CHBD_esCL839CL850&source=lnms&tbm=isch&sa=X&ved=0ahUKEwipq7abn77iAhXTK7kGHdu5AWYQ_AUIDigB&biw=1440&bih=789#imgrc=3BoxJqyuvkr-2M:

https://www.google.com/search?q=crisis+de+venezuela+2019&rlz=1C1CHBD_esCL839CL850&source=lnms&tbm=isch&sa=X&ved=0ahUKEwipq7abn77iAhXTK7kGHdu5AWYQ_AUIDigB&biw=1440&bih=789#imgrc=3BoxJqyuvkr-2M:
Suscribirse a:
Entradas (Atom)
Patógenos silenciosos.
Serotonina
Contaminantes de aguas servidas.

Los contaminantes pueden estar presentes como: Sólidos suspendidos flotantes o grandes : arenas, trapos y papel entre otros. Sólidos suspendidos pequeños y coloidales: moléculas orgánicas grandes, partículas de suelo y microorganismos entre otros. Sólidos disueltos: compuestos orgánicos y sales inorgánicas entre otros.
Efecto de la temperatura.
Proceso de aguas andinas.
Vacunas y alegias.

Vacunas contra las alergias pueden aliviar los síntomas de la rinitis alérgica (llamada fiebre del heno) y del asma causado por alergias. No es necesario aplicar una vacuna contra las alergias para cada alérgeno; lo que se hace es una mezcla de alérgenos para cada persona y se administra en una sola vacuna
Alergias.
Vacunas.
Huellas Hidricas.
Fecundación.
Ovulación.
Células reproductoras: Femeninas y Masculinas.
Ciclo menstrual.
Aparato reproductor masculino.
Aparato reproductor femenino.
Días fértiles.
Pubertad.
Espermatozoide.
Ovocitos.
Métodos de control de la natalidad.
Paternidad responsable.

Una Paternidad responsable no es solamente asumir la manutención y “reconocer legalmente el fruto de un embarazo, es un privilegio, obligación que tiene la pareja hombre y mujer de decidir con amor el número de hijos que desea tener para formar familia, ya que es la unidad básica de la sociedad humana y núcleo fundamental de la vida afectiva y moral de las personas, pilar fundamental de la existencia humana.
Maternidad responsable.
ITS

Las producen más de 30 diferentes tipos de virus, bacterias y parásitos. Las más frecuentes son la sífilis, gonorrea, clamidia, herpes, hepatitis B y C, VIH y VPH. La mayoría de las ITS se pueden prevenir usando preservativo y, en caso de que tengas alguna de estas infecciones, son tratables y muchas de ellas se curan. son enfermedades infecciosas, que pueden transmitirse de una persona a otra durante una relación sexual vaginal, anal u oral.
Vacunas
Huella hidrica.
Mensaje de Greta Thunberg.
Alergias.
Día de la Tierra.
Mezclas Heterogénea.
Mezclas homogéneas.
Los gráficos isobáricos
-
Proceso isotérmico: Si el sistema puede intercambiar energía con su medio y el proceso se realiza lentamente, de modo que el sistema tenga t...